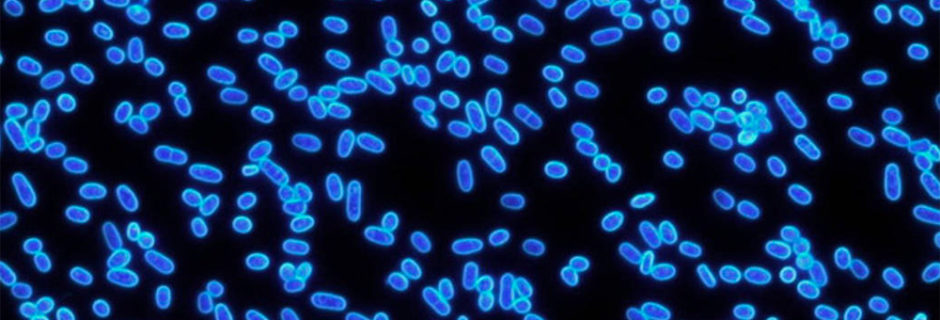

Impact Investing e Big Data, la strana coppia? Queste case history dimostrano il contrario

Le grandi sfide globali ci stanno spingendo a cambiare le abitudini di consumo e, man mano che le risorse diventano… »

Le grandi sfide globali ci stanno spingendo a cambiare le abitudini di consumo e, man mano che le risorse diventano… »

Il 2021 sarà l’anno in cui verrà inaugurata a tutti gli effetti la Presidenza di Joe Biden, motivo per il… »

Sono molti i fattori che hanno contribuito a rallentare lo spoglio dei voti in queste elezioni generali. In particolare, a… »

La pandemia di Covid-19 ha colpito alcuni settori industriali in modo particolarmente duro, e alcune “vittime” sono state maggiormente una… »

In tutto il mondo stiamo aspettando e sperando in un vaccino per il Covid-19. I mercati finanziari riflettono l’ottimismo riguardo… »

Nel ventunesimo secolo, l’umanità dovrà affrontare una delle più grandi sfide che abbia mai conosciuto: il cambiamento climatico causato dal… »

Negli ultimi sei mesi, i mercati finanziari hanno registrato rendimenti straordinari. Noi abbiamo rinunciato a viaggiare, a cenare fuori e… »
Quando ero al liceo, la biologia non mi piaceva molto. Del liceo classico amavo le materie umanistiche, soprattutto il greco,… »

Il riscaldamento globale è ormai innegabile e nessun settore è più esposto ai suoi rischi di quello assicurativo. Non si… »

Nella sola NewYork i prezzi degli appartamenti sono scesi di un 30-50% non essendoci più domanda, precipuamente a causa di… »